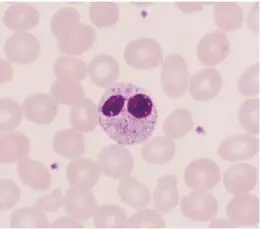
圖片描述

下圖為周邊血液抹片染色之結果,有關此圖中白血球細胞的相關敘述,下列何者最不適當?
詳細解析
本題觀念:
此題考察Pelger–Huët anomaly(PHA)之白血球核形態異常與基因病理背景,需與類似表現但病因不同的May–Hegglin anomaly(MHA)做鑑別,並理解Lamin B receptor(LBR)在核膜結構與膽固醇合成上的雙重功能。
影像分析:
從周邊血液抹片圖可見:
- 該中性球具有典型的雙葉(bilobed)或“夾鏡”(pince-nez)狀核,而非正常三至五葉核,且染色質呈緊密分塊狀,無偽胞體(pseudopodia)、無明顯Döhle小體或毒性顆粒。
- 細胞質中無大顆粒或包涵體,整體形態符合Pelger–Huët型先天性核分節不足之中性球,而非成熟度障礙或毒性變化。
選項分析
-
選項A 可能是由於 lamin B receptor (LBR)的基因突變所致
Pelger–Huët anomaly即因異常的核膜蛋白LBR基因突變造成中性球核膜與染色質交互作用異常,導致核分節不足。該異常呈常染色體顯性,異型合子雖形態異常,但臨床通常無症狀 (pubmed.ncbi.nlm.nih.gov)。 -
選項B 與May-Hegglin anomaly 最相關
May–Hegglin anomaly為MYH9基因突變所致之巨型血小板、血小板減少及白血球內含體(Döhle-like bodies)之症候群,無核分節不全的特徵。影像中並未見Döhle-like inclusion或巨型血小板,故本細胞不具MHA特色,此選項最不適當。 (ncbi.nlm.nih.gov) -
選項C 此細胞有膽固醇合成異常的情形
LBR蛋白除結構功能外,C端具有Δ14-sterol reductase活性,參與cholesterol biosynthesis。在LBR突變個體中, sterol reductase活性減弱,細胞層面會造成cholesterol合成異常。 (medlineplus.gov) -
選項D 此細胞為嗜中性球( neutrophils )
影像所示細胞核形態與中性球相符,且顆粒度、大小與周邊紅血球比例符合中性球。此為Pelger–Huët異常的中性球,選項正確。
答案解析
影像顯示典型Pelger–Huët anomaly之中性球:核分節不足呈雙葉狀,染色質緻密。此病因為LBR基因之異常造成核膜結構改變,亦伴隨LBR sterol reductase活性減損導致細胞cholesterol合成異常,選項A與C皆正確,選項D則明確為neutrophil;唯選項B乃描述May–Hegglin anomaly(MYH9突變、Döhle-like bodies、巨型血小板),與本病例毫無關聯,最不適當。
核心知識點
-
Pelger–Huët anomaly
- 臨床表現:中性球核分節不足(1–2節),染色質緻密;常染色體顯性,異型合子僅形態異常,正常功能。
- 病理機轉:LBR基因突變(lamin B receptor),影響核膜結構及與chromatin交互作用。
- LBR雙重功能:N端結構域結合lamins/heterochromatin;C端Δ14-sterol reductase參與cholesterol生合成。
-
May–Hegglin anomaly
- 特徵:巨型血小板、血小板減少、粒細胞內Döhle-like inclusions;MYH9基因突變。
- 鑑別要點:有包涵體及巨型血小板,無核分節異常。
-
鑑別診斷
- 先天性vs獲得性Pelger(myelodysplasia或藥物導致pseudo-Pelger)
- 比對形態:核形、粒度、包涵體、血小板大小與數量。
臨床重要性
誤將先天性Pelger–Huët anomaly中性球視為幼稚中性球(左移)或myelodysplasia,可導致不必要檢查或治療。認識其良性特性並鑑別其他myeloproliferative/myelodysplastic綜合徵極為關鍵。